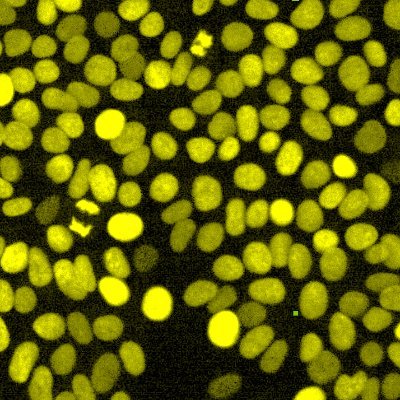
cellvoyant's profile picture. We see the future in cells

Dr. Beck Richardson
@Beck4science
I like science. BHF research fellow and Lecturer in Biomedical Sciences studying zebrafish tissue regeneration. She/her.
You might like
🔺️PhD opportunity🔺️ Looking for an enthusiastic person to join my lab @UoBPPN to pursue PhD as a part of @SWBio_DTP. Interested in circadian rhythms, feeding, and obesity? Apply now 👇 Co-supervised by the wonderful @NeuroEndo_Ex and @HughPiggins swbio.ac.uk/animal-behavio…

An exciting PhD opportunity in a great collaboration between @noelresearchlab and my lab looking at heart infections in zebrafish. Details below. Deadline is the 13th December. findaphd.com/phds/project/m…. @BatesonCentre

Fantastic opportunity to join our vibrant Vascular Team at the Comparative Biomedical Sciences Department at the @RoyalVetCollege jobs.rvc.ac.uk/vacancy.aspx?r…
Do come and join this lovely team and help us image our beautiful #zebrafish! 🚨🔬🐟
We're hiring! Applications open to join our lovely light microscopy support team here in Bristol. 🔬🧠🦠🪰🐟🧬🔬 For more details, jobs.ac.uk/job/DJZ821/tec… Deadline 16th October! 😀
📢Today is your last chance to vote in our competition to select a cover image for the @J_Cell_Sci #JCSImagingSI! Check out the beautiful images that made the final shortlisted and vote on FocalPlane! focalplane.biologists.com/2024/09/25/vot…
One day left to vote! Show my heart some love 😆
📢Voting in the #JCSImagingSI cover competition is open. We'll be highlighting all the shortlisted images this week! Vote number 7 for ‘Dynamic atrial architecture’ from @AaronJonScott (@Beck4science lab). @UoB_ArtSci @wbif_bristol @_sjcross #zebrafish focalplane.biologists.com/2024/09/25/vot…

Fellowships can be hosted in @BristolBiochem @UoBPPN @CMMBristol @BristolBioSci @BristolUniPsych Further details can be found here: jobs.ac.uk/job/DJU356/bri… Application deadline October the 28th ! Don't miss this! Please share in your networks ! @BB_STEM
Votes are open for Aaron’s beautiful picture of a #zebrafish🫀
📢Voting in the #JCSImagingSI cover competition is open. We'll be highlighting all the shortlisted images this week! Vote number 7 for ‘Dynamic atrial architecture’ from @AaronJonScott (@Beck4science lab). @UoB_ArtSci @wbif_bristol @_sjcross #zebrafish focalplane.biologists.com/2024/09/25/vot…

Applications for this PDRA position with me will be closing next week! Apply if you love cardiac excitation-contraction coupling, electrophysiology, Ca imaging and/or computer modelling! Feel free to email me for more info. bristol.ac.uk/jobs/find/deta…
The Monteiro Lab is hiring a Clinical Research Fellow to start a PhD with us! Very excited to get this project off the ground studying GATA2 variants in paediatric AML. #ZebrafishJobs #PhD More info below wix.to/LWFQBc8 or DM me Please RT
🚨 #MRCDTP25 great opportunity for a #PhD in my group @kingscardio @Kings_BHFCentre @kingsmedicine. Check Project ID CM-HD2025_02 👇 RT
Applications for @KingsCollegeLon @The_MRC Doctoral Training Partnership in Biomedical Sciences 2025 entry are now OPEN! Visit our website kcl-mrcdtp.com for more information. #MRCDTP2025
I am advertising a PhD project with @GW4BioMedDTP on daily rhythms in the brainstem and cannabinoids - please share and encourage students to apply! findaphd.com/phds/project/f…
Are you passionate about developmental biology and ready to take your research to the next level? Join our dynamic, international team exploring how the heart forms and functions during embryonic development. hubrecht.eu/job/phd-studen…

Come and join us!!
🚨🎓 New job alert: Lecturer in Physiology! 🎓🚨 The School of Physiology, Pharmacology and Neuroscience is seeking to appoint a Lecturer in Physiology. Check out the job posting via our Linktree: linktr.ee/UoBPPN #UoBPPN #JobOpening #Physiology #LecturerJobs

Come work with me! I'm please to announce that I have a Research Associate position open. Please apply if you have a passion for cardiac cell physiology and/or forward to anyone who might be interested! Contact me if you have questions. bristol.ac.uk/jobs/find/deta…
You definitely want to come and hear this wonderful fishy story from the best #zebrafish colleague ever!
Reminder to come along to Prof Chrissy Hammond's (@ChrissyLHam) Inaugural Lecture - Thursday 11th July at 6PM in Wills Memorial Building (@wills_memorial) 🐟🐠🦴🎉 Tickets on our Linktree: linktr.ee/UoBPPN #InauguralLecture #UoBPPN
A CRUK funded PhD studentship that I co-supervise with @BAIR_Head @AvaKhamseh @XiaoFu90 in sunny Edinburgh! ed.ac.uk/cancer-centre/… #zebrafish #singelcell RNAseq #liveimaging please getting in touch if you are interested!
Job alert! - development of a novel #zebrafish cancer model using CAS9 technologies, in beautiful #edinburgh funded by CRUK @CRUKScotland located in brand new @EdinUni_IRR building jobs.ac.uk/job/DGM883/pos…
United States Trends
- 1. Jalen Johnson 2,408 posts
- 2. Alix 4,785 posts
- 3. Araujo 191K posts
- 4. Hazel 9,672 posts
- 5. Wizards 6,884 posts
- 6. Godzilla 27.4K posts
- 7. Seton Hall 2,110 posts
- 8. Chelsea 663K posts
- 9. Barca 265K posts
- 10. Joey Galloway 1,075 posts
- 11. Kingston Flemings N/A
- 12. Estevao 276K posts
- 13. Bishop Boswell N/A
- 14. House Party 7,203 posts
- 15. Leftover 7,045 posts
- 16. Yamal 209K posts
- 17. Eric Morris 3,518 posts
- 18. Witkoff 72.1K posts
- 19. #DWTSFinale N/A
- 20. Barcelona 473K posts
Something went wrong.
Something went wrong.